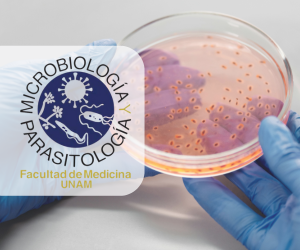

Tu nueva casa, tu increíble Facultad
"Tu nueva casa, tu increíble Facultad"
Stands de programas y servicios FacMed UNAM
Atención Nutricional

La Licenciatura en Ciencia de la Nutrición Humana ofrece a la comunidad-UNAM y población en general atención nutricia y promoción de la salud, con el fin de prevenir y atender problemas de salud relacionados con la alimentación y nutrición.
El modelo de atención se basa en los estándares nacionales e internaciones de atención nutricia. Le permitirá a las y los estudiantes aplicar y fortalecer sus competencias tanto del área clínica como en investigación.
Contáctanos
Correos:
Página web:
https://nutricion.facmed.unam.mx/index.php/atencion-nutricion/
Plan de Estudios Combinados En Medicina (PECEM)

El Plan de Estudios Combinados En Medicina (PECEM) es un programa que tiene como objetivo principal, que los alumnos con una trayectoria académica sobresaliente y con vocación para la investigación clínica, sociomédica o biomédica cursen de manera combinada los estudios de doctorado en medicina con la licenciatura en médico cirujano. Este objetivo se ha cumplido, hasta este momento, con base en estancias de investigación presenciales en laboratorios de científicos mexicanos reconocidos que permiten que nuestros alumnos obtengan experiencia y enseñanza por parte de un tutor diferente en cada semestre durante la licenciatura (7 semestres) y cuando la terminan realizan su tesis doctoral en 2 a 3 años.
Contáctanos
Correos:
Página web:
Programa de Igualdad de Género (PIGE)

El Programa de Igualdad de Género de la Facultad de Medicina coordina y da seguimiento a las acciones realizadas para cumplir los objetivos de la Política Interna de Igualdad de la Facultad de Medicina. Con este programa colabora el Programa de Estudios de Género en Salud que tiene el objetivo de formar profesionales de la salud con perspectiva de género, desarrollar investigación en perspectiva de género en salud y violencia de género en la educación médica, así como realizar actividades de difusión en estas temáticas.
Contáctanos
Correos:
prog_estudios.genero.salud@facmed.unam.mx
orientacion.genero@facmed.unam.mx
Página web:
Becas y Enlace Intitucional

Nuestra función es promover, impulsar y facilitar la comunicación con las y los alumnos que tramitan becas internas de la Facultad para el desarrollo integral del estudiante.
Fungimos como enlace entre la Facultad de Medicina y la Dirección General de Orientación y Atención Educativa para establecer los mecanismos de difusión y atención personalizadas sobre los diversos Programas de Becas y de Apoyo Universitarios de las seis licenciaturas que se imparten en la Facultad de Medicina.
Contáctanos
Correos:
Página web:
https://csc.facmed.unam.mx/index.php/becas-y-programas-de-apoyo/
Programa de Apoyo y Fomento a la Investigación Estudiantil (AFINES)

El Programa de Apoyo y Fomento a la Investigación Estudiantil (AFINES) tiene por objetivo estimular la participación de los estudiantes de la Facultad de Medicina de la UNAM en las actividades de investigación, vinculándolos a diferentes proyectos de investigación en alguna de sus áreas.
Contáctanos
Correos:
Página web:
Programa de inglés

El Programa de Inglés de la Facultad de Medicina apoya a su comunidad a alcanzar el nivel B2 de dominio del idioma en comprensión de lectura que te permite la acreditación para la titulación, para residentes médicos, además del dominio de las 4 habilidades si lo que deseas es usar el idioma inglés en tu vida cotidiana.
Contáctanos
Correos:
Página web:
Palacio de la Escuela de Medicina (PEM)

El Palacio de la Escuela es un espacio cultural universitario, enfocado en la difusión de las ciencias médicas y la cultura. En este espacio puedes encontrar el Museo de la Medicina Mexicana con sus 19 salas, la Biblioteca Histórica Dr. Nicolás León con libros enfocados en la medicina del siglo XVI al XIX, el Archivo Histórico de la Facultad y el Departamento de Historia y Filosofía de la Medicina. Las exposiciones permanentes del Museo de la Medicina Mexicana permiten interactuar con las piezas de manera didáctica y participativa, y a la vez generar cuestionamientos que conduzcan a la comprensión de la medicina mexicana y del patrimonio artístico universitario. El palacio, a su vez, ofrece exposiciones temporales que complementan los contenidos temáticos de las salas, y diversos programas que buscan insertar activamente al público como el sistema de voluntariado y servicios sociales. Además de exposiciones el Palacio de la Escuela Medicina, ofrece visitas guiadas, talleres para niños, cursos, diplomados, conciertos, eventos culturales.
Contáctanos
Número:
5556233161 y 5556233123
Correos:
Página web:
Programa de Donación de Cuerpos

Es un programa que promueve la donación voluntaria y altruista de cuerpos, para su utilización en la docencia e investigación de las ciencias médicas.
Con ello se busca proporcionar a los estudiantes de medicina y especialistas de la diferentes áreas de la salud los recursos que les permitan alcanzar la excelencia profesional.
Contáctanos
Correos:
Página web:
Programa de Investigación y Prevención del Tabaquismo

Los objetivos del Programa de Investigación y Prevención del Tabaquismo es lograr que la Facultad de Medicina sea un espacio universitario 100% libre de humo de tabaco y emisiones, generar información basada en la evidencia sobre los riesgos del consumo de los productos de tabaco y nicotina así como brindar servicios de cesación de la adicción a la nicotina a través de un programa de tratamiento en línea y finalmente difundir entre la comunidad universitaria y diferentes medios de comunicación la importancia del control del tabaco como uno de los principales factores de enfermedad y muerte prematura en la población.
Contáctanos
Correos:
Página web:
Programa de Liderazgo e Innovación Interprofesional en Salud (PLISS))

El PLIIS nace con una visión clara: formar líderes capaces de transformar el entorno de la salud a través de la innovación, el trabajo colaborativo y un compromiso profundo con la sociedad. Este programa está diseñado para estudiantes comprometidos, curiosos, con vocación de servicio y dispuestos a aprender más allá del aula.
El programa se desarrolla en dos fases fundamentales. La primera, enfocada en el desarrollo de habilidades nucleares, es una etapa formativa donde aprenderás a pensar estratégicamente, comunicarte efectivamente, colaborar en equipos diversos y liderar con empatía. La segunda fase se centra en el diseño e implementación de proyectos innovadores, que abordan problemáticas urgentes en cuatro ejes clave: acción social, cambio climático, sostenibilidad y salud digital. Todo esto, desde un enfoque interprofesional, ético, igualitario y con impacto real en la sociedad. PLIIS no es solo un programa, es una comunidad. Una comunidad de estudiantes, docentes y profesionales que comparten la convicción de que es posible mejorar la salud en México y el mundo a través del conocimiento, la colaboración y la innovación. Si tú eres una persona con iniciativa, compromiso y pasión por transformar el mundo desde la salud, el PLIIS es para ti.
Contáctanos
Correos:
Programa de Salud Mental (PROSAM)

El Programa de Salud Mental de la Facultad de Medicina surge como una respuesta integral a las crecientes demandas de bienestar emocional en la comunidad universitaria. Dirigido por un equipo multidisciplinario de especialistas en salud mental, el programa articula acciones clínicas, preventivas y educativas para promover el autocuidado, detectar oportunamente factores de riesgo y brindar acompañamiento psicológico y psiquiátrico a estudiantes, docentes y personal administrativo. A través de consultas, talleres, capacitaciones, campañas de sensibilización y herramientas autogestivas, el programa busca fortalecer las habilidades emocionales, la resiliencia y el compromiso académico, reconociendo que el bienestar psicológico es un componente esencial para la formación de profesionales de la salud empáticos, éticos y con sentido humano.
Contáctanos
Correos:
Página web:
Programa de Salud Sexual Integral (PROSSI)

El Programa de Salud Sexual Integral (PROSSI), es un área que ofrece intervenciones educativas y orientación sobre salud sexual y reproductiva a la comunidad estudiantil de la Facultad de Medicina.
Se ofertan diversos módulos que están disponibles a lo largo del ciclo escolar, con la finalidad de aumentar el conocimiento sobre el uso correcto de los métodos anticonceptivos, prevención de Infecciones de Transmisión Sexual (ITS), salud menstrual, entre otros temas.
Además, contamos con un boletín de publicación mensual llamado Sapiosex, en el cuál se abordan temas de sexualidad basado en el modelo de Educación Integral en Sexualidad (EIS) y en la comunicación pública de la ciencia.
Si quieres saber más, puedes encontrarnos en la oficina que se encuentra en el basamento del edificio «G» ¡Conócenos!
Contáctanos
Correos:
Página web:
Programa de Sostenibilidad (FacMed Sostenible)

Nuestro objetivo es promover una cultura de sostenibilidad en la formacion medica y la gestion institucional, integrando practicas responsables y la equidad social, para contribuir al desarrollo de una medicina etica, preventiva y comprometida con las futuras generaciones
Contáctanos
Correos:
Programa Institucional de Ética y Bioética

El Programa Institucional Ética y Bioética FACMED tiene como objetivos principales fomentar en los miembros de comunidad de la Facultad de Medicina una actitud ética y bioética que guíe sus desempeños académicos y profesionales, además promover reflexiones sobre la ética y bioética a partir de temáticas y dinámicas aplicables de manera transversal a toda la comunidad de la Facultad de Medicina, a través de distintas actividades, generando reflexiones que trasciendan los espacios de aprendizaje formal.
Contáctanos
Correos:
Página web:
Programa Institucional de Tutoría (PIT)

El Programa Institucional de Tutoría tiene el objetivo de apoyar el proceso de formación del alumnado de la Facultad de Medicina mediante el acompañamiento tutorial durante su trayectoria académica para mejorar su desempeño y contribuir a su formación personal y profesional.
Contáctanos
Correos:
atencion.tutorias@facmed.unam.mx
Página web:
Puntos CulturaUNAM

Accede a conciertos, charlas, talleres y muchas actividades culturales mas con tus Puntos CulturaUNAM.
Contáctanos
Correos:
atencion@comunidad.cultura.unam.mx
Página web:
Sistema Universidad Abierta y Educación a Distancia (SUAyED)

La Secretaría del SUAyED (Sistema Universidad Abierta y Educación a Distancia) de la Facultad de Medicina de la UNAM es la encargada de brindar una opción innovadora de formación profesional en el área de la salud. Impulsa y extiende oferta educativa a través de acciones en modalidades abierta, a distancia y mixta al alumnado, personal académico y profesionales del área de la salud.
Contáctanos
Correos:
Página web:
Unidad de Movilidad Académica y Vinculación Interinstitucional (MAVI)

Somos la Unidad de Movilidad Académica y Vinculación Interinstitucional.
Apoyamos a estudiantes, egresados, académicos y personal en su camino hacia la internacionalización, ya sea a través de intercambios, proyectos colaborativos, congresos, o programas como el Virtual Language Exchange y la Calidación Documental Académica.
Somos el vínculo entre tus sueños y el mundo, conectándote con oportunidades académicas, científicas y culturales dentro y fuera del país.
¡Expande tus horizontes, conoce, experimenta y vive todas las oportunidades que MAVI tiene para ti!
Contáctanos
Correos:
Página web:
Stands académicos
Anatomía (Primer año)
BIENVENIDO AL DEPARTAMENTO CON MÁS HISTORIA DE LA FACULTAD, DONDE APRENDERÁS LAS ESTRUCTURAS DEL CUERPO HUMANO COMO BASE FUNDAMENTAL DE TU FURURA PRÁCTICA MÉDICA.
Contáctanos
Correos:
anatomia.ensenanza@facmed.unam.mx
Página web:
Embriología y Genética (Primer año)

Visita guiada a las aulas del DEyG e información como es el departamento
Contáctanos
Correos:
Página web:
Salud Digital (1° y 2° año)

El Departamento de Informática Biomédica de la Facultad de Medicina de la UNAM impulsa la formación de profesionales de la salud capaces de integrar conocimientos en tecnología, ciencia de datos y medicina para mejorar la atención clínica, la gestión de servicios y la investigación biomédica. A través de la docencia, la investigación y la innovación tecnológica, promueve el desarrollo y uso ético de sistemas de información en salud, análisis de datos clínicos y soluciones digitales que optimicen los procesos en el ámbito médico. Su labor se orienta a fortalecer la toma de decisiones en salud, garantizar la calidad de la información y fomentar la equidad en el acceso a tecnologías sanitarias, con base en el respeto a los derechos humanos y la protección de datos personales.
Contáctanos
Número:
5618743905
Correos:
Página web:
Farmacología (Segundo año)

En el Departamento de Farmacología nos dedicamos a la enseñanza, investigación y difusión del conocimiento en farmacología. Nuestra misión es formar profesionales de la salud de pregrado y posgrado con una sólida base científica, pensamiento crítico y compromiso ético.
¡Te damos la más cordial bienvenida a esta nueva etapa académica!
Contáctanos
Correos:
farma.ensenanza@facmed.unam.mx
Página web:
Biología Celular y Tisular (Primer año)

Histología se escribe con H.
Somos una gran familia encargada de impartir la asignatura de Biología Celular e Histología Médica, la cual te enamorará desde el principio con sus increíbles imágenes de las estructuras tisulares capturadas a través del Microscopio, convirtiéndola en un verdadero deleite visual para tu aprendizaje.
¡Te esperamos!
Contáctanos
Correo:
Página web:
Integración de Ciencias Médicas (1° y 2° año)

El DICiM es un departamento académico que contribuye en la formación de profesionales de la salud, vinculando la docencia, la investigación y la tecnología a través de herramientas didácticas para la adquisición de competencias profesionales, capacitando y certificando estudiantes de pregrado y posgrado en el área de la salud e instancia educativas hospitalarias dedicadas al desarrollo de actividades educativas y clínicas, para el beneficio de la sociedad mexicana.
Contáctanos
Correos:
Página web:
Salud Pública (1° y 2° año)

El Departamento de Salud Pública de la Facultad de Medicina de la UNAM se dedica a la formación de médicas y médicos con una visión integral, crítica y comprometida con el bienestar colectivo. A través de la enseñanza, investigación y acción comunitaria, promueve el análisis de los determinantes sociales de la salud, el uso de herramientas epidemiológicas y la formulación de intervenciones que fortalezcan los servicios de salud pública. Su labor está orientada a mejorar la salud de la población, con base en la equidad, la participación social y el respeto a los derechos humanos.
Contáctanos
Número:
55 56237000 ext. 43098
Página web:
Fisiología (Segundo año)

La asignatura de Fisiología se brinda en el segundo año de la carrera, y aborda de manera integrativa el funcionamiento del cuerpo humano.
Contáctanos
Número:
56232367
Página web:
https://fisiologia.facmed.unam.mx/
Bioquímica y Biología Molecular (1° y 2° año)

El Departamento de Bioquímica participa en la docencia impartiendo las asignaturas de Bioquímica y Biología Molecular en primer año, e Inmunología en segundo año.
Estas asignaturas son pilares fundamentales en la formación del estudiantado de medicina, y forman parte de las bases biomédicas en el Plan de Estudios 2010. Su relevancia radica en que proporcionan las bases conceptuales y moleculares necesarias para comprender el funcionamiento del cuerpo humano en la salud y en la enfermedad.
Contáctanos
Correos:
Página web:
Psiquiatría y Salud Mental (Primer año)

¿Quiénes somos?
Somos el Departamento de Psiquiatrìa y Salud Mental de la Facultad de Medicina-UNAM, enfocados en enseñanza, investigaciòn, atención y clínica para estudiantes y trabajadores universitarios.
Equipo multidisciplinario: psiquiatras, psicólogos clínicos y trabajadores sociales.
Objetivo principal: «Promover, prevenir, diagnosticar, tratar y dar seguimiento a los problemas de salud mental de la comunidad universitaria, mediante un modelo integral que incluya la atención clínica, la docencia y la investigación.»
Contáctanos
Correo:
jefatura_psiquiatria@facmed.unam.mx
Página web:
Cirugía (Segundo año)

El Departamento de Cirugía de la Facultad de Medicina le da la bienvenida a todos los alumnos de nuevo ingreso y los invita a conocer las actividades que realiza en la preparación de las nuevas generaciones de médicos, así como en cursos de alta especialidad e investigación
Contáctanos
Correos:
alejandro.rodriguez@facmed.unam.mx
Página web:
Microbiología y Parasitología (Segundo año)
El Departamento de Microbiología y Parasitología de la UNAM te abre las puertas a un mundo fascinante, donde lo diminuto tiene un impacto gigante. Aquí no solo estudiarás bacterias, virus y parásitos, sino que también aprenderás cómo interactúan con nuestro cuerpo y el medio ambiente. Imagina simular brotes de enfermedades, diseñar estrategias para combatirlas y explorar modelos 3D de microorganismos para entender su funcionamiento a detalle. ¡Prepárate para una aventura científica que te convertirá en un experto en la lucha contra las enfermedades infecciosas!
Correos:
juancarlos.cadena@facmed.unam.mx
Página web:
Stands Deportivos
Actividades Deportivas FacMed

En Actividades Deportivas contamos con 11 deportes y talleres para nuestra comunidad FacMed: Futbol, basquetbol, voleibol, americano/tochito, acuáticas, yoga, zumba, baile, kickboxing, lima lama, porras y animación.
Contamos con deporteca y ludoteca, material disponible para préstamo a alumnxs de la FacMed cuando quieran despejarse un rato de sus actividades académicas.
Ofrecemos orientación a actividades de Deporte UNAM (más de 90 disciplinas), acceso a instalaciones deportivas, torneos, cursos deportivos, etc.
Destaca también el Buitreviernes social, una actividad que se realiza cada 2-3 semanas donde hay juegos, dinámicas, y se suman a participar departamentos, grupos de interés, servicios FacMed, etc.; además, al participar en las dinámicas, se pueden obtener pases dobles para ver los partidos de los Pumas MX femenil y varonil, de soccer y americano.
También contamos con torneos de fútbol, basquetbol y voleibol a lo largo del año.
Es el espacio perfecto para salir de la rutina, activarnos físicamente y fortalecer los lazos entre nuestra comunidad FacMed.
Contáctanos
Correos:
Página web:
https://csc.facmed.unam.mx/index.php/actividades-deportivas-y-recreativas/
Dirección General del Deporte Universitario (DGDU)

La Dirección General del Deporte Universitario se encarga de orientar a las y los estudiantes, al conjunto de la comunidad universitaria y a la población en general acerca de las actividades deportivas y las vinculadas a la cultura física que coadyuvan en su formación integral. Tiene como objetivo promover la identificación de talentos deportivos entre las y los miembros de la comunidad universitaria para potenciar sus capacidades hacia el alto rendimiento, de modo tal que representen a la UNAM en las máximas competiciones estatales, regionales, nacionales e internacionales; así como fomentar la activación física constante entre la comunidad universitaria y la población en general, a efectos de que obtengan beneficios en el ámbito de la salud y fortalezcan su formación integral.
Contáctanos
Correos:
Página web:
Stands Grupos Estudiantiles
AANS UNAM: Medical Student Chapter

AANS UNAM Medical Student Chapter es el capítulo estudiantil más grande de América Latina, avalado por la American Association of Neurological Surgeons (AANS). Está conformado por estudiantes de la Facultad de Medicina, FES Iztacala y FES Zaragoza de la Universidad Nacional Autónoma de México (UNAM), unidos por el interés común de promover la Neurocirugía y su integración con otras disciplinas médicas.
Nos enfocamos en la difusión académica, científica y profesional de la Neurocirugía y las Neurociencias, a través de actividades totalmente gratuitas dirigidas a estudiantes de pregrado. Entre ellas se incluyen conferencias, simposios, cursos, talleres, mentorías, rotaciones e iniciativas de investigación.
¡Contáctanos a traves de nuestras redes sociales!
AEIR UNAM: Asociación Estudiantil en Inmunología y Reumatología

AEIR UNAM es un grupo estudiantil enfocado en el aprendizaje, investigación, divulgación y difusión de la inmunología y reumatología, busca fomentar la búsqueda de conocimiento desde ciclos básicos para correlacionar lo aprendido con el área clínica
Contáctanos
Número:
9613177713
Página web:
CIG UNAM: Grupo de Interés en Cardiología

El Grupo de Interés en Cardiología (CIG) surge con el firme propósito de enriquecer la formación médica mediante actividades enfocadas en la educación, la investigación y la divulgación científica en el área de la cardiología. Desde nuestra fundación, estamos orgullosos de contar con la afiliación al American College of Cardiology (ACC), así como con convenios con instituciones de alto prestigio como el Instituto Nacional de Cardiología “Ignacio Chávez” y CardioAcademic.
Nos consolidamos como un espacio académico donde los estudiantes encuentran oportunidades para participar activamente en conferencias con especialistas, talleres teórico-prácticos (como disección cardiaca e interpretación básica de ECG), y proyectos de investigación que fomentan la producción científica de calidad.
Contamos con presencia en distintas sedes universitarias, incluyendo coordinaciones activas en la Facultad de Medicina de Ciudad Universitaria, FES Iztacala y FES Zaragoza, lo que nos permite ampliar nuestro alcance y generar un mayor impacto académico en la comunidad estudiantil.
Entre nuestros objetivos destacan: fortalecer la presencia en congresos nacionales e internacionales, aumentar la producción de publicaciones científicas, expandir nuestras actividades educativas y fomentar el crecimiento del grupo a nivel local, nacional e internacional.
CIG se distingue por su compromiso con la excelencia, el trabajo en equipo y la pasión por el conocimiento en cardiología, guiando a futuras generaciones de médicos en su desarrollo académico y profesional.
Contáctanos
Correos:
Página web:
https://convocatoriacig.my.canva.site/sitio-oficial-cig-unam
GIPED: Grupo de Interés de Pediatría

GIPED (Grupo de Interés de Pediatría) es una iniciativa estudiantil de la Facultad de Medicina, creada por y para estudiantes, que busca enriquecer la formación académica y práctica de aquellos compañeros interesados en la especialidad de Pediatría. Nos dedicamos a ofrecer una experiencia formativa integral, que incluye ponencias magistrales, clases especiales, actividades de voluntariado y rotaciones clínicas, con el fin de sentar las bases de futuros profesionales de la salud pediátrica altamente capacitados y comprometidos.
Contáctanos
Número:
56 14273890
IMIG-UNAM: Grupo de Interés en Medicina Interna

Somos un Grupo de Interés en Medicina Interna que tiene como objetivo promover la participación estudiantil en actividades de aprendizaje científico y humanístico relacionadas a la medicina interna y sus subespecialidades.
Correos:
PsychSIGN UNAM

Grupo de estudiantes de pregrado y posgrado de la Facultad de Medicina de la UNAM con interés en la psiquiatría y salud mental.
Estamos comprometidos con el desarrollo de la investigación, educación y divulgación de información confiable en materia de salud mental y psiquiatría para todo público.
Contáctanos
Correo:
Página web:
SEOF: Sociedad Estudiantil de Oftalmología

Nosotros somos la sociedad estudiantil de oftalmología, estamos encargados de difundir información a través de conferencias o actividades sobre los nuevos avances de la oftalmología y así pueda crecer más el interés por la especialidad.
Contáctanos
Correo:
ACO-G UNAM: Grupo de Interés de Ginecología y Obstetricia

Te damos la más cordial bienvenida a la Facultad y te invitamos a conocer el Grupo de Interés en Ginecología y Obstetricia CU, capítulo estudiantil avalado por el Colegio Americano de Obstetras y Ginecólogos (ACOG).
Nuestro objetivo es fomentar el interés y la formación académica en el área de la salud de la mujer, mediante actividades educativas, talleres, ponencias, eventos clínicos y de vinculación profesional.
Nuestra misión: Crear espacios de aprendizaje en obstetricia y ginecología que acerquen a la comunidad médica universitaria a una atención integral, ética y basada en evidencia.
Nuestra visión: Ser un grupo formativo que contribuya a preparar a los futuros médicos para los retos de la práctica profesional, siempre priorizando el bienestar de las mujeres y de la sociedad mexicana.
Si te apasiona la medicina con enfoque humano y quieres complementar tu formación desde ahora, este es tu lugar.
Contáctanos
Número:
5613775057
Aerosapiens: Aerospace Medicine Interest Group

¡Prepárense para despegar con AeroSapiens!
¿Listos para explorar los límites de la medicina más allá de la Tierra? AeroSapiens, el grupo estudiantil de Medicina Aeroespacial, está a punto de aterrizar con actividades emocionantes y completamente nuevas en “Circuitos FacMed». Esta es su oportunidad de sumergirse en un campo fascinante que cada vez cobra más relevancia.
Nuestro objetivo es claro: despertar el interés, divulgar conocimientos y fomentar la enseñanza de la Medicina Aeroespacial en nuestra comunidad.
¡Vengan a conocernos y descubran cómo pueden formar parte de esta aventura que los llevará a las estrellas!
Contáctanos
Correos:
GIAMSI: Grupo de Interés en Antropología Médica y Salud Intercultural

GIAMSI es un grupo de interés estudiantil que busca fomentar la formación intercultural en salud mediante la integración de conocimientos antropológicos en la educación médica.
¡Contáctanos a traves de nuestras redes sociales!
GISOS: Grupo de Interés en Sostenibilidad

El Grupo de Interés en Sostenibilidad (GISOS) surge como un espacio estudiantil comprometido con la promoción de la conciencia ambiental, la salud planetaria y el desarrollo de iniciativas sostenibles dentro y fuera del entorno universitario. Nuestro enfoque se centra en generar propuestas que integren la sostenibilidad con la formación médica y las acciones comunitarias, fomentando así una cultura de responsabilidad social y ambiental entre los futuros profesionales de la salud.
Contáctanos
Números:
5586126434
LEMEP: Liga Estudiantil Médica Puma

La Liga Estudiantil Médica Puma (LEMEP) es una organización estudiantil de la Facultad de Medicina, afiliada a la Asociación Mexicana de Médicos en Formación (AMMEF) y a la Federación Internacional de Asociaciones de Estudiantes de Medicina (IFMSA). Desarrolla diversas actividades académicas y sociales con el propósito de complementar de manera integral la formación de las y los estudiantes, ofreciéndoles herramientas y oportunidades dentro de su ámbito profesional.
Cuenta con 5 comités permanentes de proyectos (salud pública, derechos humanos y paz, derechos sexuales y reproductivos, publicaciones médicas y educación médica) y 2 comités de intercambios (nacionales e internacionales).
Contáctanos
Correos:
Página web:
Sangre Puma

Sangre puma es un grupo estudiantil de la Facultad de Medicina de la UNAM que busca aumentar las cifras de donaciones sanguíneas altruistas en el país a través de diversas actividades como campañas, juegos, platicas, etc…
¡Contáctanos a traves de nuestras redes sociales!
SIGN- UNAM: Student Interest Group of Neurology

SIGN (Student Interest Group in Neurology) es un grupo estudiantil con interés en las neurociencias, fundado en México bajo la tutela de la American Academy of Neurology (AAN). Desde su inicio en 2014, ha reunido a estudiantes de medicina apasionados por la neurología, con el objetivo de fomentar la docencia, investigación y difusión científica en áreas tanto básicas como clínicas de las neurociencias. Este capítulo estudiantil busca complementar la formación académica de los alumnos mediante actividades educativas y profesionales, promoviendo una comunidad activa y capacitada en el desarrollo de conocimientos neurocientíficos, con miras a impactar de manera significativa en los distintos campos de la neurología.
Contáctanos
Correos:
Página web:
https://www.aan.com/tools-resources/student-interest-group-in-neurology
ACS Surgery Interest Group UNAM: American College of Surgeons

Somos un grupo de interés en cirugía creado por estudiantes para estudiantes. Fundado con el objetivo de elaborar estrategias para apoyar en su formación médico-quirúrgica a la comunidad de estudiantes de medicina de la UNAM que demuestren un interés genuino por las especialidades quirúrgicas.
Contáctanos
Correo:
ASCO-OSIG UNAM: Oncology Student Interest Group

ASCO-OSIG UNAM es un grupo estudiantil dedicado a la divulgación, investigación y formación en el campo de la oncología. Nuestro objetivo es acercar a los estudiantes de medicina a esta especialidad a través de talleres, conferencias, campañas de prevención y actividades académicas. Promovemos el aprendizaje colaborativo y el pensamiento crítico en torno al cáncer, sus implicaciones médicas y sociales, y fomentamos la participación activa en proyectos que impacten a la comunidad.
¡Únete y descubre todo lo que puedes aportar y aprender en el mundo de la oncología!
Contáctanos
Correo:
GIEUM: Grupo de Interés Estudiantil de Urgencias Médicas

Nuestro nombre es GIEUM, el Grupo de Interés Estudiantil de Urgencias Médicas, y somos una asociación hecha por alumnos para alumnos y cualquier personal de la salud en formación. Nosotros buscamos difundir sensibilización, educación médica y preparación acerca de enfermedades y situaciones que se presentan en el servicio de urgencias médicas. Te invitamos a que te acerques a nuestro stand en la bienvenida de la generación 2026 para saber más información sobre nosotros, además, de que nos encantaría contar con tu participación en actividades culturales y puedas conocer todas nuestras propuestas que ofrecemos para tu preparación a lo largo de todo el año. No importa si eres un alumno nuevo en esta comunidad, en la Facultad de Medicina y GIEUM te damos una cálida bienvenida y te invitamos a que conozcas lo grandioso e interesante que es nuestra práctica como médicos cuando estemos en situaciones donde, la velocidad de nuestras decisiones correctas y de nuestras manos, nos pueden brindar herramientas para afrontar distintos escenarios y poder salvar vidas aplicando la medicina de urgencias.
¡Sean bienvenidos, generación 2026!
Contáctanos
Correos:
GITYO: Grupo de Interés en Traumatología y Ortopedia

¡Hola! Somos el grupo de interés en Traumatología y Ortopedia, un espacio diseñado para inspirarte y mostrarte todo lo que esta fascinante especialidad tiene para ofrecer. Organizamos ponencias con especialistas, talleres prácticos para aprender técnicas como inmovilización y colocación de yesos, además de simulaciones y casos clínicos que te ayudarán a desarrollar tus habilidades desde el inicio. También encontrarás oportunidades para conectar con doctores y conocer más sobre el impacto de esta área en la medicina.
¡Contáctanos a traves de nuestra redes sociales!
Página web:
MISSION BRAIN CHAPTER UNAM

Mission:brain es una organización sin fines de lucro con el objetivo de proporcionar cirugías a pacientes de bajos recursos con alguna patología neuroquirúrgica, en cualquier parte del mundo.
Nuestra principal tarea es ofrecer a los estudiantes de medicina y carreras a fin, herramientas para no solo hacer crecer su conocimiento, si no que, también desarrollen habilidades y aptitudes a lo largo de su formación académica y como consecuencia, lograr el objetivo anteriormente mencionado.
Contáctanos
Correos:
Página web:
SEN UNAM: Sociedad Estudiantil de Nefrología

SEN UNAM es un grupo de interés dedicado a difundir información útil sobre Nefrología a través de diversas actividades académicas que permitan crear un acercamiento con la comunidad estudiantil permitiéndoles obtener adecuados conocimientos en beneficio de su formación como médicos generales.
Contáctanos
Correos:
sociedadestudiantildenefro@gmail.com
Página web:

